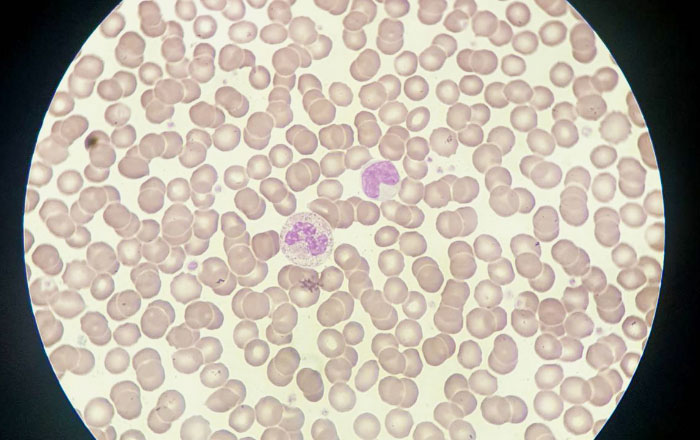
時間帯によって痛みに波がある理由:免疫力の差

歯の治療全般
歯の痛み方が時間帯で変わるのはなぜ?~原因と応急処置について解説

「布団に入ると歯がズキズキ痛み出す」
「朝起きた瞬間、顎や歯全体に重い痛みを感じる」
このように、歯の痛みに波があることで「本当に歯が悪いのかな…それとも気のせいかな」と不安を感じている方はいらしゃいませんか?
歯の痛みが時間帯によって変化するのには、実は、自律神経や血流といった身体の仕組みと歯の病気が関係しています。
そこで今回は、夜・朝・食後といった時間帯で歯が痛む原因と応急処置について解説します。
なぜ時間帯によって痛みに波があるの?
就寝時に強い痛みが出るといったように、特定の時間に痛みが強くなるのは、冒頭でも触れた体のメカニズムが関係しています。
自律神経の切り替わり

私たちの体は、活動的な時に働く交感神経と、リラックスしている時に働く副交感神経の2つがバランスを取り合っています。
そして日中は交感神経が優位になり、興奮作用のあるアドレナリンが分泌され、痛みを感じにくくなります。仕事や家事に集中していると痛みを忘れるのはこのためです。
一方、夜間は副交感神経が優位になり、体を休めるためにリラックスモードに入ります。するとアドレナリンの分泌が減り、痛みの感覚が鋭敏になります。
つまり、夜になると痛いのではなく、夜は痛みに敏感になっている状態になるのです。
血流の変化と頭部への圧力

お風呂上がりや就寝時、横になると歯が痛くなることはありませんか?これは血流が関係しています。
入浴や飲酒などによって副交感神経が優位になると血管が広がり、血流が良くなります。血の巡りが良くなるのは健康には良いことですが、炎症を起こしている歯にとっては、神経を内側から圧迫することになり、痛みを増幅させてしまうのです。
また、横になると、立っている時よりも頭部に血液が集まりやすくなります。これにより、歯の内部の圧力が高まり、ズキズキとした痛みを感じやすくなるのです。
免疫力の差
免疫細胞として知られる白血球にはいくつかの種類があります。その中でも(※)顆粒球(かりゅうきゅう)と呼ばれる免疫細胞には、細菌やウイルスに対する殺菌作用があり、体内に入り込んだ細菌や寄生虫などを除去してくれます。
この顆粒球は自律神経の影響を強く受けており、体が活発に動いている昼間など、交感神経が優位な時に増えやすいのが特徴です。
反対に夜間やリラックスしている時は顆粒球が作られにくくなります。細菌に対する防御力が一時的に弱まるため、夜間に歯の痛みを感じやすくなるのです。
(※)顆粒球は殺菌作用のある顆粒を持つ細胞の総称で、血中に最も多く含まれ、病原体を貪食する好中球(こうちゅうきゅう)、寄生虫やアレルギー反応を防御する好酸球(こうさんきゅう)、好塩基球(こうえんききゅう)の、主に3種からなります。
【時間帯別】歯の痛みの原因として考えられる病気
それでは時間帯によって起こりやすい歯の痛みの原因をいくつか挙げてみましょう。
朝の痛み

「朝起きると奥歯が痛い」「顎が疲れている」こうした症状は物理的な力が原因であることがほとんどです。
【考えられる歯や歯茎の病気】
- 歯根膜炎(しこんまくえん)
- 咬合性外傷(こうごうせいがいしょう)
歯根膜炎(しこんまくえん)とは、歯の根っこを覆っている歯根膜という薄い靭帯のような組織が炎症を起こしている状態です。虫歯ではないのに、「歯が浮いた感じ」や「噛むと痛い」という症状が出ます。
咬合性外傷は、過度な噛む力によって歯を支える骨や組織が傷ついている状態です。歯周病を悪化させる原因の一つとして考えられています。

これらの主な原因は、寝ている間の歯ぎしり・食いしばりです。私たちは通常、食事の時間を含めても、1日に上下の歯が接触している時間は20分程度といわれていますが、歯ぎしりによる弊害のコラムでもお話ししたように、睡眠中は無意識のうちに、体重の数倍もの強い力で長時間ギリギリと歯をこすり合わせたり、食いしばったりすることがあるのです。
このように一晩中強い力で揺さぶられ続けた歯や歯根膜は、朝起きる頃には疲労困憊の状態です。これが、起床時の「歯が浮く」「顎が痛い」という症状につながります。
食後の痛み

甘いものを食べたときだけ歯が痛くなる経験をした方もいらっしゃるかもしれません。
【考えられる歯や歯茎の病気】
- 虫歯
- 知覚過敏
虫歯は、ミュータンス菌などの虫歯菌が作り出す乳酸によって歯が溶かされる病気です。虫歯というと歯が痛くなると思われがちですが、実は浅い虫歯ではさほど痛くなりません。
しかし、糖分が入ってくると、虫歯菌が活発に酸を作り出し、この高濃度の糖分が象牙質の細い管(象牙細管)に入り込むと、浸透圧の変化で神経を刺激するため、痛みやしみる感覚を覚えるようになります。
知覚過敏は、歯肉が下がるなどして歯の象牙質が外部に露出した状態になり、温度の刺激に敏感になる状態です。虫歯ではありませんが、甘いものでも知覚過敏が誘発されることもあります。
夜の痛み

夜だけ歯が痛くなるといった状態は、虫歯が進行している可能性が高いといえます。
【考えられる歯や歯茎の病気】
- 歯髄炎(しずいえん)
- 根尖性歯周炎(こんせんせいししゅうえん)
コラムでも解説した歯髄炎は、虫歯が進行し、歯の中にある神経(歯髄)まで細菌が到達して炎症を起こしている状態です。夜になるとズキズキと脈打つような痛みが生じることがあります。
根尖性歯周炎は、神経が死んでしまった歯の根の先に起こる炎症性の病気です。歯の根の先に膿がたまると周囲を強く圧迫するため、その圧力で歯が痛くなります。
根尖性歯周炎については、その虫歯、ついつい放置していませんか?と、その顎の痛み…もしかしたら虫歯が原因かも?のコラムでも解説しておりますので、併せてご参照ください。
すぐにできる応急処置
歯医者はもう閉まっているけれど、痛みが気になる…そんな時に、ご自宅でできる応急処置をご紹介します。ただし、これらはあくまでも応急処置です。なるべく早めに歯科医院を受診して正確な判断を仰ぎましょう。
患部を冷やす

頬の上から、濡れタオルやタオルで巻いた保冷剤、冷却シートなどで冷やしてください。血流を少し抑えることで痛みが和らぐことがあります。
市販の鎮痛剤を飲む

我慢せずに、ロキソニンやバファリンなどの市販の痛み止めを服用してください。
頭を高くして寝る

枕を高くしたり、クッションを使ったりして、頭の位置を心臓より高くして寝てください。頭部への血液の集中を防ぎ、内圧を下げることで痛みが軽減されやすくなります。
口の中を清潔にする

食べカスが詰まっていると神経を圧迫して痛むことがあります。歯ブラシやフロスで優しく汚れを取り除き、ぬるま湯でうがいをしましょう。
痛みの波は見過ごさず、早めに歯科医院を受診しましょう
今回お伝えしたように、歯の痛みは、自律神経の切り替わりや血流の変化、免疫力の低下など、体のリズムが関係しています。
日中に痛みが引いたとしても治ったわけではなく、交感神経の働きで痛みを感じにくくなっているだけかもしれません。痛みの波を見過ごして放置してしまうと、症状が悪化する恐れがあります。なるべく早く歯科医院を受診しましょう。

受診の際は、「いつ、どのような時に痛むか」をスマートフォンやメモ帳に記録しておき、詳しくお伝えいただけると診断がよりスムーズになります。
ポラリス歯科・矯正歯科では、各種治療はもちろん、医療法人社団千仁会の専門医が、原因が分かりにくい歯の痛みについても丁寧で的確な診断を行っています。時間帯によって変化する症状にお悩みの方も、札幌駅すぐのポラリス歯科・矯正歯科までお気軽にご相談ください。






